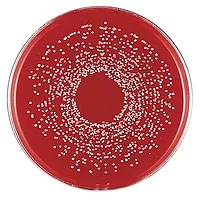

Automation and Cost Savings Using Photometric Analysis

Like many other industries, changes in food safety and quality testing are often the result of the migration of existing technologies to the food testing laboratory. For decades, discrete photometric analysis has been employed successfully in clinical laboratories. Offering faster, more reproducible results with less sample waste, discrete analyzers have played a major role in the evolution and automation of clinical tests. More recently, this technology has been adapted to work with various environmental and industrial applications, including food and beverage analysis.
Efficiency and Productivity in Analysis
All food products require analysis as part of a quality management program; they are analyzed throughout the development process, during production and sometimes after a product has already been delivered to the market. Speed and automation are the key factors for labs that perform many tests and want to improve and simplify analytical procedures.
Thermo Scientific Gallery, a new, discrete photometric analyzer, is fully automated and conveniently sized, offering excellent analytical performance for colorimetric, enzymatic and electrochemical measurements. Several system parameters can be predefined for specific applications, and a wide variety of reagents help optimize the analysis in tests such as fermentation processes, ingredients in food samples and water quality.
Automated Operation
Gallery’s high level of automation means that it is easy to operate. The analyzer arrives ready for immediate analysis; it doesn’t need any warm-up time or reagent priming. Start-up and shutdown protocols are automated and, once loaded, the analyzer automates all necessary steps, providing a walk-away time of up to 2 hours. Sample pretreatment is minimal; generally, centrifugation or filtration is adequate to prepare the samples. Additionally, the low sample volume needed per test is one of the advantages of discrete analysis.
Several blanking possibilities are available to eliminate sample matrix effects. Results are flagged automatically in case of abnormal values, out-of-limit control values or repeats. Reporting is possible as printouts or electronically as PDF files. Spreadsheet reporting is also possible for further calculations.
Reliable Technology
Gallery provides an integrated platform for two measurement techniques, photometric and electrochemical (ECM), which can be run in parallel. Discrete cell technology allows for simultaneous measurement of several different tests for the same sample, eliminating method changeover time. Each individual reaction cell is isolated and temperature-stabilized, thus providing highly controlled reaction conditions. Gallery is able to achieve very low detection levels, and its sophisticated dilution features help to manage a wide concentration range without user intervention. Results are ready within minutes, translating to remarkable saving in hands-on time. The wavelength range covers filter configurations from 275 nm to up to 880 nm. The new, optional ECM unit supports conductivity measurements over a broad range and uses ion selective electrodes for pH measurement. Sodium and potassium determinations will be added in the future.
Flexible and Economical to Use
The instrument’s flexible loading capacity, up to 45 samples or 30 reagents simultaneously, contributes to its convenience and ease-of-use. An on-board barcode reader enables automatic sample and reagent identification. Samples, reagents and consumables can be loaded at any time without interrupting the analysis in progress. Application parameters allow up to four reagent additions in each test, offering automation even for the most complex methods. Inventory management includes associated calibrations and reagent lot data.
In addition, Gallery’s unique, low-volume cuvette design makes it economical to use. It guarantees low reagent costs and minimizes the amount of reagent waste. Cuvettes are disposable, so there is no need for washing to prevent carry-over.
Optimized System Solutions
System applications are available for different sugars, acids and alcohols, as well as for nitrate, phosphate, sulphate, calcium, magnesium, urea, ammonia and chloride. A wide range of calibrators and controls support the testing. The application data is loadable from a file or from a two-dimensional barcode by the barcode scanner.
Ready-to-use system kits eliminate time-consuming reagent preparation, allowing additional cost savings. Kit sizes and on-board stability are optimized, and bar-coded vials provide reliable and easy identification. Reagent usage and expiration date are automatically monitored in real-time.
Compact Design
Gallery’s compact design occupies only a small footprint, facilitating installation in any laboratory. The analyzer is fully self-contained and does not require external water or drainage connections. Analyzer uptime is maximized by minimal daily and weekly maintenance. Although any laboratory would benefit from the use of a Gallery system, it is particularly attractive to laboratories with space limitations or for those who perform specific enzymatic testing, such as a small winery.
Summary
The Thermo Scientific Gallery is an automated system that allows users to simplify their food, beverage and water testing to realize both time and financial savings. Once loaded, the system allows an analyst to walk away for several hours and return later to find accurate, reliable results.
www.thermoscientific.com/gallery
Looking for quick answers on food safety topics?
Try Ask FSM, our new smart AI search tool.
Ask FSM →